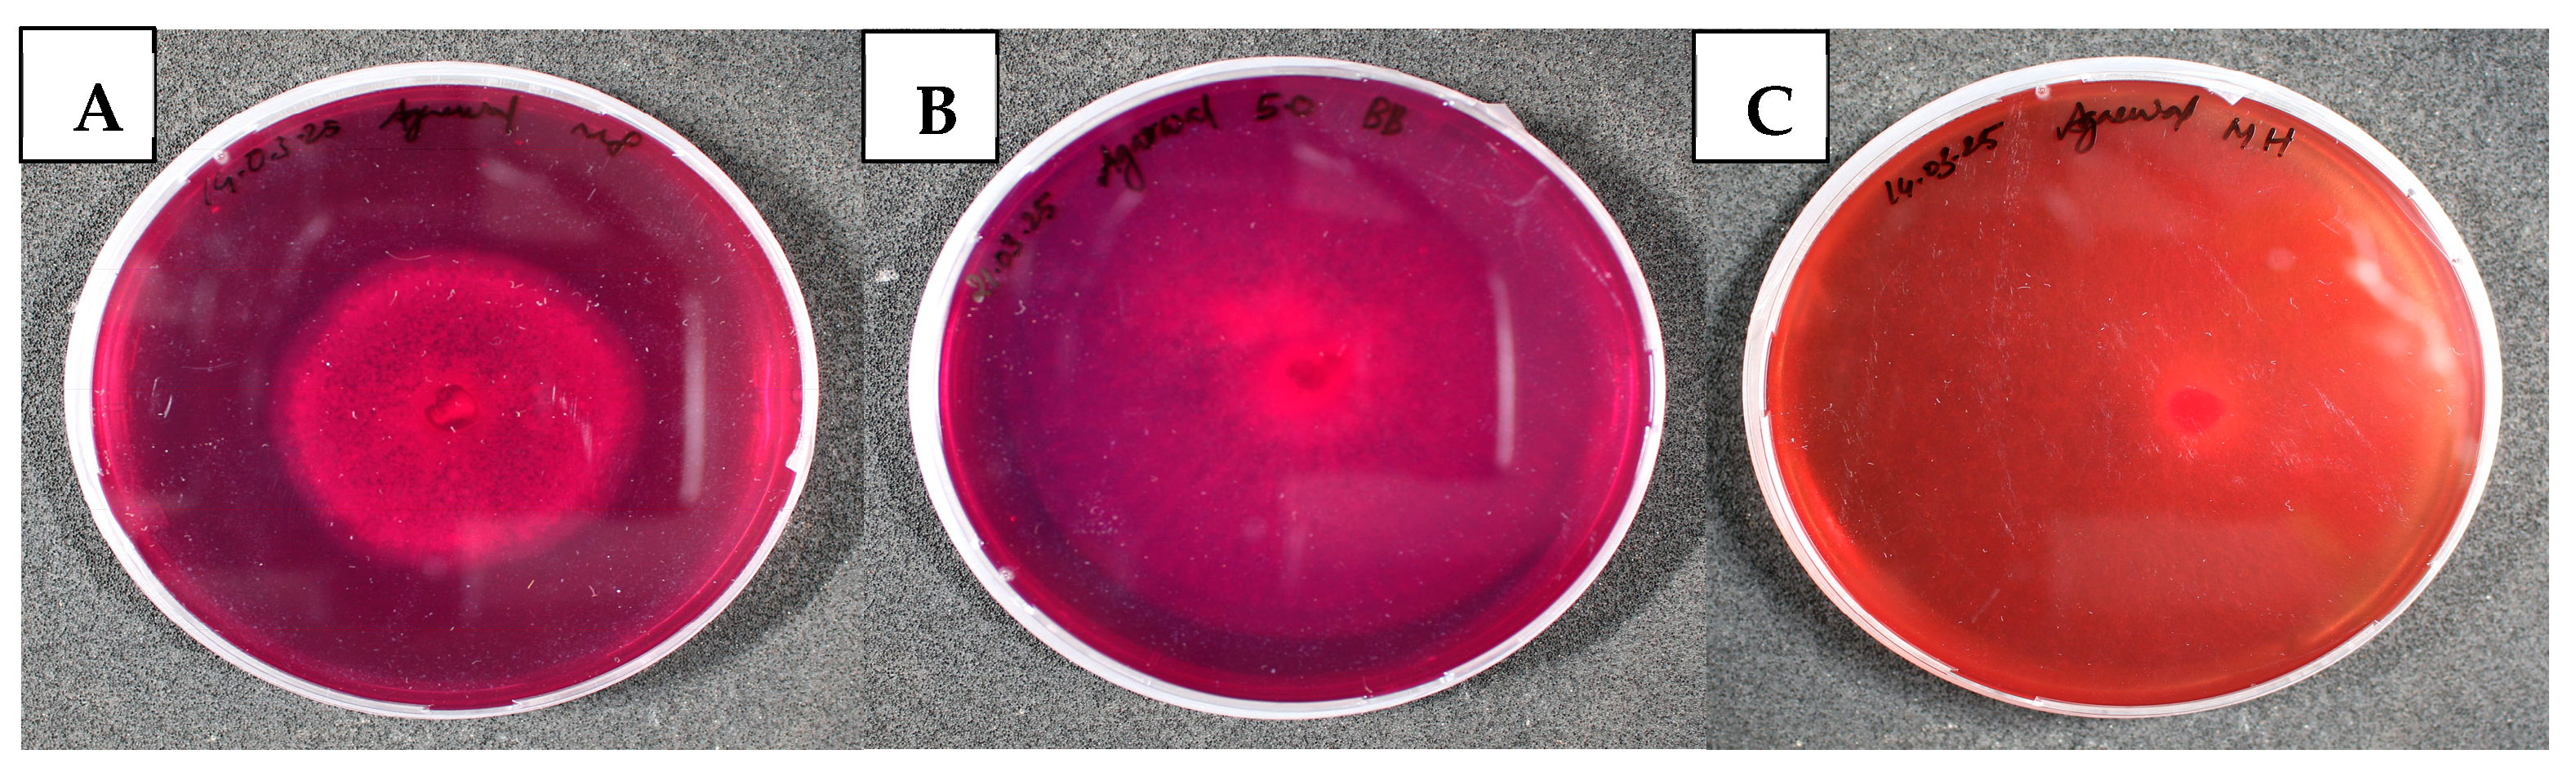
Sustainability 17 05897 g004
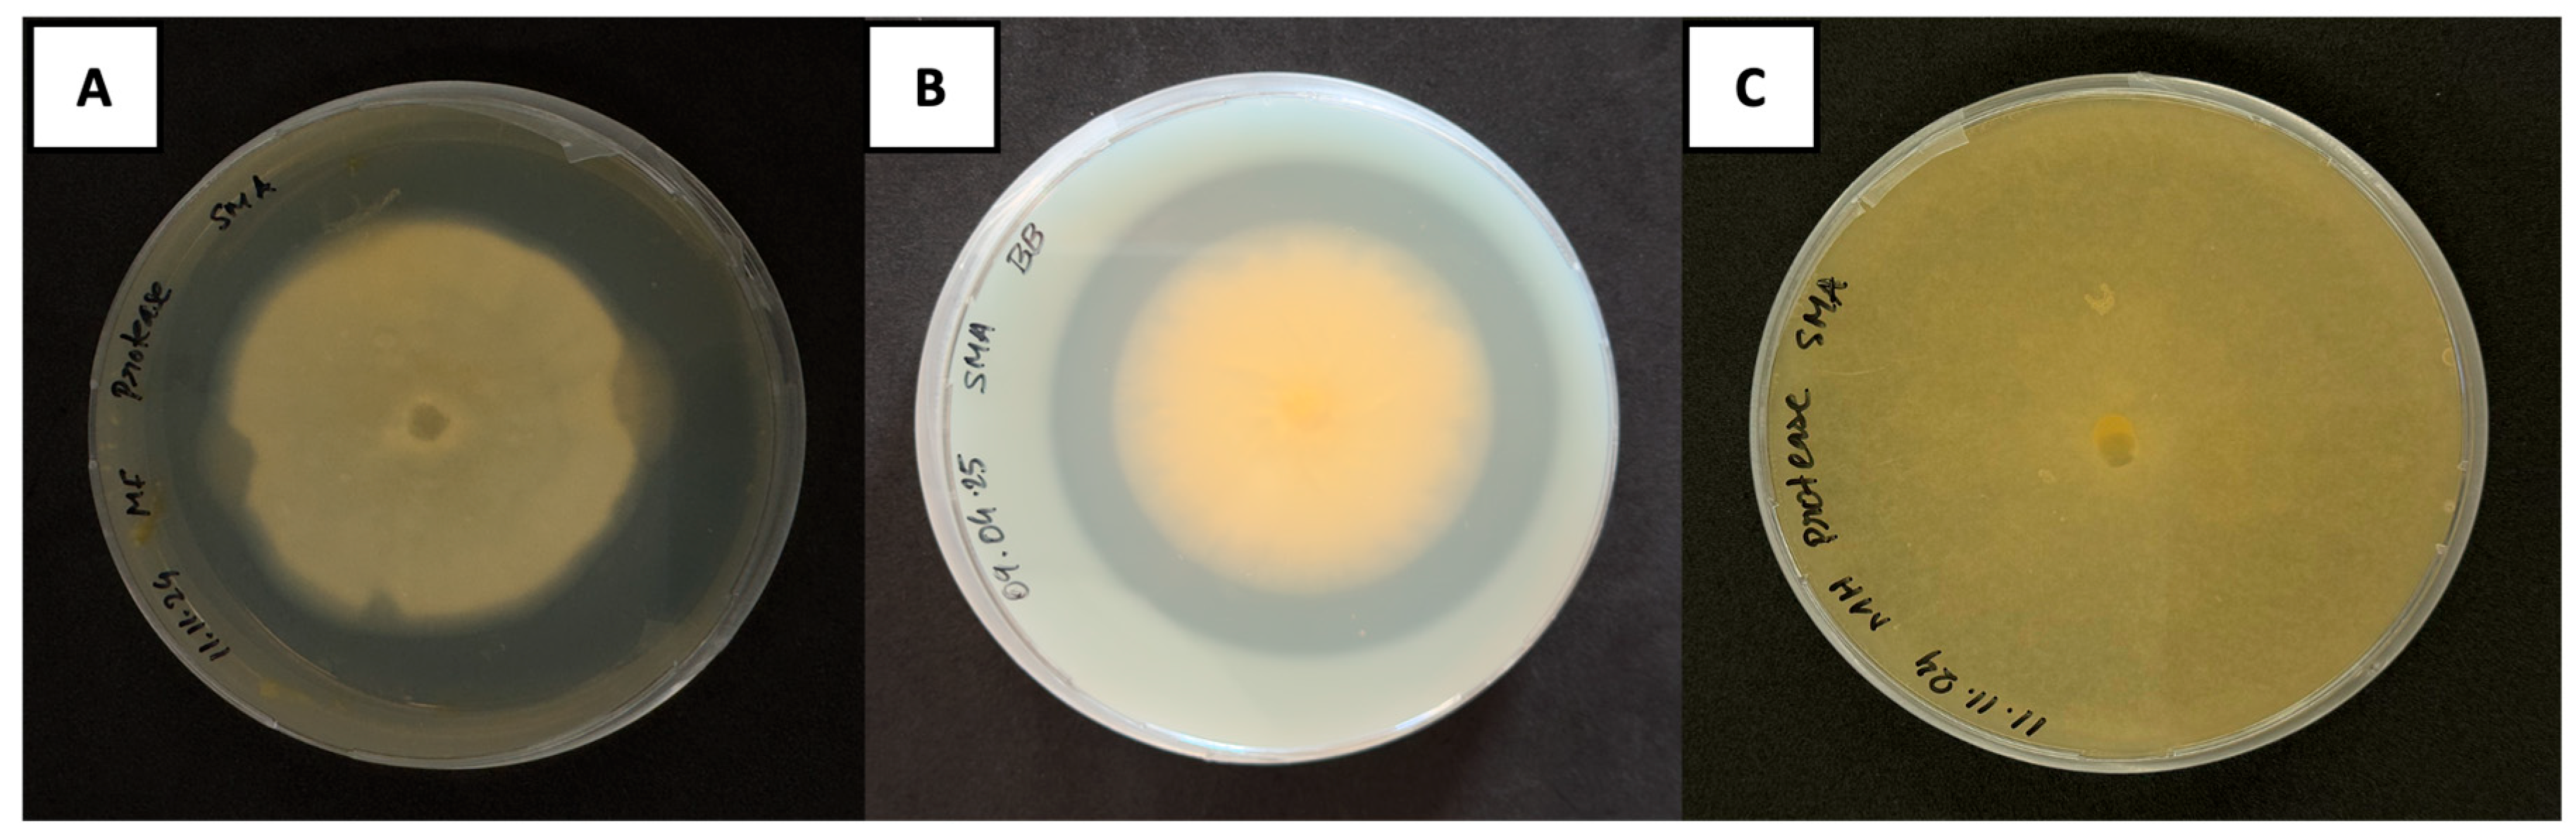
Sustainability 17 05897 g007

Efficacy of Entomopathogenic Fungi for Sustainable Biocontrol of Fungus Gnat (Bradysia difformis) in Peat-Free Substrates: A Laboratory Study
Abstract
1. Introduction
2. Materials and Methods
2.1. Efficacy of Entomopathogenic Fungi to Manage Fungus Gnat Larvae from Becoming Adults
2.2. Larval Survival on Pure Fungal Cultures
2.3. Chitinase Production Assay
2.3.1. Preparation of Culture Filtrates
2.3.2. Preparation of Colloidal Chitin
2.3.3. Qualitative Detection of Chitinase Enzyme
2.3.4. Assay for Chitinase Activity
2.4. Protease Production Assay
2.5. Root Colonizing Ability of EMPFs
2.5.1. Preparation of ½ Murashige and Skoog (MS) Medium
2.5.2. Seed Sterilization and Germination
2.5.3. Inoculation of Test Fungi
2.5.4. Assessment of Root Colonization and Plant Growth Effects
3. Results
3.1. Effect of Entomopathogenic Fungi to Control the Bradysia Difformis Larvae
3.2. Larval Survival on Pure Fungal Cultures
3.2.1. Qualitative Detection of Chitinase Activity
3.2.2. Assay for Chitinase Activity
3.3. Qualitative Identification of Protease Production
3.4. Effect of Fungal Colonization in Petunia and Basil Plants
4. Discussion
5. Conclusions
Supplementary Materials
Author Contributions
Funding
Institutional Review Board Statement
Informed Consent Statement
Data Availability Statement
Acknowledgments
Conflicts of Interest
Abbreviations
| EMPF | Entomopathogenic fungi |
| MS | Murashige and Skoog |
| PDA | Potato Dextrose Agar |
| ANOVA | Analysis of Variance |
| DSMZ | German Collection of Microorganisms and Cell Cultures |
| DNA | Deoxyribonucleic Acid |
| NCBI | National Center for Biotechnology Information |
| rpm | Revolutions per minute |
| NaOCl | Sodium hypochlorite |
| (NH4)2SO4 | Ammonium sulfate |
| MgSO4·7H2O | Magnesium sulfate heptahydrate |
| KH2PO4 | Monopotassium phosphate |
| °C | Degrees Celsius |
| RH | Relative humidity |
| IPM | Integrated Pest Management |
| U | Units |
| HSD | Honestly Significance Difference |
| L:D | Light:Dark |
| SE | Standard error |
| d | Days |
| ×g | Relative centrifugal force (times gravity) |
| g | Gram |
| L, mL | Liter, milliliter |
| cm, µm | Centimeter, micrometer |
References
- Babytskiy, A.I.; Moroz, M.S.; Kalashnyk, S.O.; Bezsmertna, O.O.; Voitsekhivska, O.V.; Dudiak, I.D. New findings of pest sciarid species (Diptera, Sciaridae) in Ukraine, with the first record of Bradysia difformis. Biosyst. Divers. 2019, 27, 131–141. [Google Scholar] [CrossRef]
- Harris, M.A.; Oetting, R.D.; Gardner, W.A. Use of entomopathogenic nematodes and a new monitoring technique for control of fungus gnats, Bradysia coprophila (Diptera: Sciaridae), in floriculture. Biol. Control 1995, 5, 412–418. [Google Scholar] [CrossRef]
- Tomalak, M.; Piggott, S.; Jagdale, G.B. Glasshouse applications. In Nematodes as Biocontrol Agents; CABI Publishing Wallingford: Oxfordshire, UK, 2005; pp. 147–166. [Google Scholar]
- Menzel, F.; Smith, J.E.; Colauto, N.B. Bradysia difformis Frey and Bradysia ocellaris (Comstock): Two additional neotropical species of black fungus gnats (Diptera: Sciaridae) of economic importance: A redescription and review. Ann. Entomol. Soc. Am. 2003, 96, 448–457. [Google Scholar] [CrossRef]
- Freeman, P. Sciarid flies, Diptera; Sciaridae. In Handbooks for the Identification of British Insects 9, Part 6; The Royal Entomological Society of London: St Albans, UK, 1983; p. 68. [Google Scholar]
- Binns, E.S. Fungus gnats (Diptera: Mycetophilidae/Sciaridae) and the role of mycophagy in soil: A review. Revue d'Écologie et de Biologie du Sol 1981, 18, 77–90. [Google Scholar]
- Gillespie, D.R.; Menzies, J.G. Fungus gnats vector Fusarium oxysporum f. sp. radicislycopersici 1. Ann. Appl. Biol. 1993, 123, 539–544. [Google Scholar] [CrossRef]
- Ludwig, S.W.; Oetting, R.D. Evaluation of medium treatments for management of Frankliniella occidentalis (Thripidae: Thysanoptera) and Bradysia coprophila (Diptera: Sciaridae). Pest. Manag. Sci. 2001, 57, 1114–1118. [Google Scholar] [CrossRef]
- Nielsen, G.R. Fungus Gnats. Available online: https://ipm.ucanr.edu/PMG/PESTNOTES/pn7448.html (accessed on 29 April 2025).
- Wilkinson, J.D.; Daugherty, D.M. Comparative development of Bradysia impatiens (Diptera: Sciaridae) under constant and variable temperatures. Ann. Entomol. Soc. Am. 1970, 63, 1079–1083. [Google Scholar] [CrossRef]
- Cloyd, R.A. Management of fungus gnats (Bradysia spp.) in greenhouses and nurseries. Floric. Ornam. Biotechnol. 2008, 2, 84–89. [Google Scholar]
- Kekkilä Professional. The Control of Fungus Gnats in Your Greenhouse. Available online: https://www.kekkilaprofessional.com/growing-tips/the-control-of-fungus-gnats-in-your-greenhouse/ (accessed on 18 April 2025).
- Ma, J.; Chen, S.; Moens, M.; Han, R.; De Clercq, P. Efficacy of entomopathogenic nematodes (Rhabditida: Steinernematidae and Heterorhabditidae) against the chive gnat, Bradysia odoriphaga. J. Pest Sci. 2013, 86, 551–561. [Google Scholar] [CrossRef]
- Bai, G.-Y.; Xu, H.; Fu, Y.-Q.; Wang, X.-Y.; Shen, G.-S.; Ma, H.-K.; Feng, X.; Pan, J.; Gu, X.-S.; Guo, Y.-Z.; et al. A comparison of novel entomopathogenic nematode application methods for control of the chive gnat, Bradysia odoriphaga (Diptera: Sciaridae). J. Econ. Entomol. 2016, 109, 2006–2013. [Google Scholar] [CrossRef]
- Shan, T.; Zhang, H.; Chen, C.; Chen, A.; Shi, X.; Gao, X. Low expression levels of nicotinic acetylcholine receptor subunits Boα1 and Boβ1 are associated with imidacloprid resistance in Bradysia odoriphaga. Pest Manag. Sci. 2020, 76, 3038–3045. [Google Scholar] [CrossRef] [PubMed]
- Shah, P.A.; Pell, J.K. Entomopathogenic fungi as biological control agents. Appl. Microbiol. Biotechnol. 2003, 61, 413–423. [Google Scholar] [CrossRef] [PubMed]
- Hajek, A.E.; McManus, M.L.; Junior, I.D. A review of introductions of pathogens and nematodes for classical biological control of insects and mites. Biol. Control 2007, 41, 1–13. [Google Scholar] [CrossRef]
- Lacey, L.A.; Frutos, R.; Kaya, H.K.; Vail, P. Insect pathogens as biological control agents: Do they have a future? Biol. Control 2001, 21, 230–248. [Google Scholar] [CrossRef]
- Amobonye, A.; Bhagwat, P.; Singh, S.; Pillai, S. Enhanced xylanase and endoglucanase production from Beauveria bassiana SAN01, an entomopathogenic fungal endophyte. Fungal Biol. 2021, 125, 39–48. [Google Scholar] [CrossRef]
- Bale, J.S.; Van Lenteren, J.C.; Bigler, F. Biological control and sustainable food production. Philos. Trans. R. Soc. B Biol. Sci. 2008, 363, 761–776. [Google Scholar] [CrossRef]
- Gabarty, A.; Salem, H.M.; Fouda, M.A.; Abas, A.A.; Ibrahim, A.A. Pathogencity induced by the entomopathogenic fungi Beauveria bassiana and Metarhizium anisopliae in Agrotis ipsilon (Hufn.). J. Radiat. Res. Appl. Sci. 2014, 7, 95–100. [Google Scholar] [CrossRef]
- Coombes, C.A.; Hill, M.P.; Moore, S.D.; Dames, J.F. Entomopathogenic fungi as control agents of Thaumatotibia leucotreta in citrus orchards: Field efficacy and persistence. BioControl 2016, 61, 729–739. [Google Scholar] [CrossRef]
- Andreadis, S.S.; Cloonan, K.R.; Bellicanta, G.S.; Paley, K.; Pecchia, J.; Jenkins, N.E. Efficacy of Beauveria bassiana formulations against the fungus gnat Lycoriella ingenua. Biol. Control 2016, 103, 165–171. [Google Scholar] [CrossRef]
- Dehghani, M.; Vidal, J.R.A. Combined application of a biopesticide and a botanical compound to control fungus gnats Bradysia impatiens on different host plants. Combined Application of a Biopesticide and a Botanical Compound to Control Fungus Gnats Bradysia impatiens, p. 83. Available online: https://ediss.uni-goettingen.de/handle/21.11130/00-1735-0000-0008-59C5-6 (accessed on 20 June 2022).
- Tóthné Bogdányi, F.; Petrikovszki, R.; Balog, A.; Putnoky-Csicsó, B.; Gódor, A.; Bálint, J.; Tóth, F. Current knowledge of the entomopathogenic fungal species Metarhizium flavoviride Sensu Lato and its potential in sustainable pest control. Insects 2019, 10, 385. [Google Scholar] [CrossRef]
- Vega, F.E.; Posada, F.; Aime, M.C.; Pava-Ripoll, M.; Infante, F.; Rehner, S.A. Entomopathogenic fungal endophytes. Biol. Control 2008, 46, 72–82. [Google Scholar] [CrossRef]
- Vega, F.E. The use of fungal entomopathogens as endophytes in biological control: A review. Mycologia 2018, 110, 4–30. [Google Scholar] [CrossRef] [PubMed]
- Akutse, K.S.; Maniania, N.K.; Fiaboe, K.K.M.; Van den Berg, J.; Ekesi, S. Endophytic colonization of Vicia faba and Phaseolus vulgaris (Fabaceae) by fungal pathogens and their effects on the life-history parameters of Liriomyza huidobrensis (Diptera: Agromyzidae). Fungal Ecol. 2013, 6, 293–301. [Google Scholar] [CrossRef]
- Gathage, J.W.; Lagat, Z.O.; Fiaboe, K.K.M.; Akutse, K.S.; Ekesi, S.; Maniania, N.K. Prospects of fungal endophytes in the control of Liriomyza leafminer flies in common bean Phaseolus vulgaris under field conditions. BioControl 2016, 61, 741–753. [Google Scholar] [CrossRef]
- Jaber, L.R. Grapevine leaf tissue colonization by the fungal entomopathogen Beauveria bassiana sl and its effect against downy mildew. BioControl 2015, 60, 103–112. [Google Scholar] [CrossRef]
- Dash, A.; Singh, A.P.; Chaudhary, B.R.; Singh, S.K.; Dash, D. Effect of silver nanoparticles on growth of eukaryotic green algae. Nano-micro Lett. 2012, 4, 158–165. [Google Scholar] [CrossRef]
- Sasan, R.K.; Bidochka, M.J. Antagonism of the endophytic insect pathogenic fungus Metarhizium robertsii against the bean plant pathogen Fusarium solani f. sp. phaseoli. Can. J. Plant Pathol. 2013, 35, 288–293. [Google Scholar] [CrossRef]
- Jaber, L.R.; Salem, N. Endophytic colonisation of squash by the fungal entomopathogen Beauveria bassiana (Ascomycota: Hypocreales) for managing Zucchini yellow mosaic virus in cucurbits. Biocontrol Sci. Technol. 2014, 24, 1096–1109. [Google Scholar] [CrossRef]
- Bruck, D.J. Fungal entomopathogens in the rhizosphere. BioControl 2010, 55, 103–112. [Google Scholar] [CrossRef]
- Pava-Ripoll, M.; Angelini, C.; Fang, W.; Wang, S.; Posada, F.J.; Leger, R.S. The rhizosphere-competent entomopathogen Metarhizium anisopliae expresses a specific subset of genes in plant root exudate. Microbiology 2011, 157, 47–55. [Google Scholar] [CrossRef]
- Liao, X.; O’Brien, T.R.; Fang, W.; Leger, R.J.S. The plant beneficial effects of Metarhizium species correlate with their association with roots. Appl. Microbiol. Biotechnol. 2014, 98, 7089–7096. [Google Scholar] [CrossRef] [PubMed]
- Lopez, D.C.; Sword, G.A. The endophytic fungal entomopathogens Beauveria bassiana and Purpureocillium lilacinum enhance the growth of cultivated cotton (Gossypium hirsutum) and negatively affect survival of the cotton bollworm (Helicoverpa zea). Biol. Control 2015, 89, 53–60. [Google Scholar] [CrossRef]
- Jaber, L.R.; Enkerli, J. Effect of seed treatment duration on growth and colonization of Vicia faba by endophytic Beauveria bassiana and Metarhizium brunneum. Biol. Control 2016, 103, 187–195. [Google Scholar] [CrossRef]
- Zheng, Y.; Liu, Y.; Zhang, J.; Liu, X.; Ju, Z.; Shi, H.; Mendoza-Mendoza, A.; Zhou, W. Dual role of endophytic entomopathogenic fungi: Induce plant growth and control tomato leafminer Phthorimaea absoluta. Pest. Manag. Sci. 2023, 79, 4557–4568. [Google Scholar] [CrossRef]
- Lacey, L.A. Microbial Control of Insect and Mite Pests: From Theory to Practice; Academic Press: Cambridge, MA, USA, 2016. [Google Scholar]
- Mantzoukas, S.; Lagogiannis, I. Endophytic colonization of pepper (Capsicum annum) controls aphids (Myzus persicae Sulzer). Appl. Sci. 2019, 9, 2239. [Google Scholar] [CrossRef]
- Mantzoukas, S.; Grammatikopoulos, G. The effect of three entomopathogenic endophytes of the sweet sorghum on the growth and feeding performance of its pest, Sesamia nonagrioides larvae, and their efficacy under field conditions. Crop Prot. 2020, 127, 104952. [Google Scholar] [CrossRef]
- Quesada-Moraga, E.; Herrero, N.; Zabalgogeazcoa, Í. Entomopathogenic and nematophagous fungal endophytes. In Advances in Endophytic Research; Springer: New Delhi, India, 2014; pp. 85–99. [Google Scholar]
- Lefort, M.-C.; McKinnon, A.C.; Nelson, T.L.; Glare, T. Natural occurrence of the entomopathogenic fungi Beauveria bassiana as a vertically transmitted endophyte of Pinus radiata and its effect on above-and below-ground insect pests. N. Z. Plant Prot. 2016, 69, 68–77. [Google Scholar] [CrossRef]
- Kabaluk, J.T.; Ericsson, J.D. Metarhizium anisopliae seed treatment increases yield of field corn when applied for wireworm control. Agron. J. 2007, 99, 1377–1381. [Google Scholar] [CrossRef]
- Schneider, P.; Aarau, O. Entomologisches Praktikum; Verlag H. R. Sauerländer & Co.: Aarau, Switzerland, 1947. [Google Scholar]
- Mkiga, A.M.; Mohamed, S.A.; Plessis, H.D.; Khamis, F.M.; Akutse, K.S.; Ekesi, S. Metarhizium anisopliae and Beauveria bassiana: Pathogenicity, horizontal transmission, and their effects on reproductive potential of Thaumatotibia leucotreta (Lepidoptera: Tortricidae). J. Econ. Entomol. 2020, 113, 660–668. [Google Scholar] [CrossRef]
- Roberts, W.K.; Selitrennikoff, C.P. Plant and bacterial chitinases differ in antifungal activity. Microbiology 1988, 134, 169–176. [Google Scholar] [CrossRef]
- Agrawal, T.; Kotasthane, A.S. Chitinolytic Assay of Indigenous Trichoderma Isolates Collected from Different Geographical Locations of Chhattisgarh in Central India. 2012. Available online: http://www.springerplus.com/content/1/1/73 (accessed on 10 March 2025).
- Tronsmo, A.; Harman, G.E. Detection and quantification of N-acetyl-β-D-glucosaminidase, chitobiosidase, and endochitinase in solutions and on gels. Anal. Biochem. 1993, 208, 74–79. [Google Scholar] [CrossRef] [PubMed]
- Zghair, A. Enzymatic efficacy of some types of Aspergillus fungi isolated from some manuscripts and its effect on some of the physical and chemical properties of the manuscripts. In IOP Conference Series: Materials Science and Engineering; Institute of Physics Publishing: Bristol, UK, 2019. [Google Scholar] [CrossRef]
- Cenis, J.L. Rapid extraction of fungal DNA for PCR amplification. Nucleic Acids Res. 1992, 20, 2380. [Google Scholar] [CrossRef]
- Ajvad, F.T.; Madadi, H.; Michaud, J.P.; Zafari, D.; Khanjani, M. Combined applications of an entomopathogenic fungus and a predatory mite to control fungus gnats (Diptera: Sciaridae) in mushroom production. Biol. Control 2020, 141, 104101. [Google Scholar]
- Lotfy, D.E.S.; Moustafa, H.Z. Field evaluation of two entomopathogenic fungi; Beauveria bassiana and Metarhizium anisopliae as a biocontrol agent against the spiny bollworm, Earias insulana Boisduval (Lepidoptera: Noctuidae) on cotton plants. Egypt. J. Biol. Pest Control 2021, 31, 78. [Google Scholar] [CrossRef]
- Zhu, G.; Ding, W.; Xue, M.; Zhao, Y.; Li, M.; Li, Z. Identification and Pathogenicity of a New Entomopathogenic Fungus, Mucor hiemalis (Mucorales: Mucorales), on the Root Maggot, Bradysia odoriphaga (Diptera: Sciaridae). J. Insect Sci. 2022, 22, 2. [Google Scholar] [CrossRef] [PubMed]
- Ge, W.; Du, G.; Zhang, L.; Li, Z.; Xiao, G.; Chen, B. The time–concentration–mortality responses of western flower thrips, Frankliniella occidentalis, to the synergistic interaction of entomopathogenic fungus Metarhizium flavoviride, insecticides, and diatomaceous earth. Insects 2020, 11, 93. [Google Scholar] [CrossRef] [PubMed]
- Liu, S.; Lai, Y.; Du, G.; Chen, B. Investigation on tolerance of Metarhizium flavoviride Ma130821 to environmental stress factors and responses on biological control of larvae of Potosia brevitarsis Lewis. Entomol. Res. 2022, 52, 459–475. [Google Scholar] [CrossRef]
- Cloyd, R.A.; Dickinson, A. Effect of Bacillus thuringiensis subsp. israelensis and neonicotinoid insecticides on the fungus gnat Bradysia sp nr. coprophila (Lintner) (Diptera: Sciaridae). Pest Manag. Sci. 2006, 62, 171–177. [Google Scholar] [CrossRef]
- Juliya, R.F. Phylogeny, chitinase activity, and pathogenicity of Beauveria, Metarhizium and Lecanicillium species against cowpea aphid, Aphis craccivora Koch. Int. J. Trop. Insect Sci. 2020, 40, 309–314. [Google Scholar] [CrossRef]
- Gebremariam, A.; Chekol, Y.; Assefa, F. Extracellular enzyme activity of entomopathogenic fungi, Beauveria bassiana and Metarhizium anisopliae and their pathogenicity potential as a bio-control agent against whitefly pests, Bemisia tabaci and Trialeurodes vaporariorum (Hemiptera: Aleyrodidae). BMC Res. Notes 2022, 15, 117. [Google Scholar] [CrossRef]
- Fang, W.; Leng, B.; Xiao, Y.; Jin, K.; Ma, J.; Fan, Y.; Feng, J.; Yang, X.; Zhang, Y.; Pei, Y. Cloning of Beauveria bassiana chitinase gene Bbchit1 and its application to improve fungal strain virulence. Appl. Env. Microbiol. 2005, 71, 363–370. [Google Scholar] [CrossRef] [PubMed]
- Dhawan, M.; Joshi, N. Enzymatic comparison and mortality of Beauveria bassiana against cabbage caterpillar Pieris brassicae LINN. Braz. J. Microbiol. 2017, 48, 522–529. [Google Scholar] [CrossRef] [PubMed]
- Roberts, D.W.; Hajek, A.E. Entomopathogenic fungi as bioinsecticides. In Frontiers in Industrial Mycology; Springer: Berlin/Heidelberg, Germany, 1992; pp. 144–159. [Google Scholar]
- Bidochka, M.J.; Khachatourians, G.G. Purification and properties of an extracellular protease produced by the entomopathogenic fungus Beauveria bassiana. Appl. Env. Microbiol. 1987, 53, 1679–1684. [Google Scholar] [CrossRef]
- Fer, H.L.W. Release of Proteinase from Mycelitrn of Mucor hiemalis. 1967. Available online: https://journals.asm.org/journal/jb (accessed on 12 April 2025).
- Schulz, B.; Boyle, C. The endophytic continuum. Mycol. Res. 2005, 109, 661–686. [Google Scholar] [CrossRef]
- Hardoim, P.R.; van Overbeek, L.S.; Berg, G.; Pirttilä, A.M.; Compant, S.; Campisano, A.; Döring, M.; Sessitsch, A. The hidden world within plants: Ecological and evolutionary considerations for defining functioning of microbial endophytes. Microbiol. Mol. Biol. Rev. 2015, 79, 293–320. [Google Scholar] [CrossRef]
- Sena, L.; Mica, E.; Valè, G.; Vaccino, P.; Pecchioni, N. Exploring the potential of endophyte-plant interactions for improving crop sustainable yields in a changing climate. Front. Plant Sci. 2024, 15, 1349401. [Google Scholar] [CrossRef]
- Porras-Alfaro, A.; Bayman, P. Hidden fungi, emergent properties: Endophytes and microbiomes. Annu. Rev. Phytopathol. 2011, 49, 291–315. [Google Scholar] [CrossRef]
- Rodriguez, R.J.; White, J.F., Jr.; Arnold, A.E.; Redman, R.S. Fungal endophytes: Diversity and functional roles. New Phytol. 2009, 182, 314–330. [Google Scholar] [CrossRef]

| Treatments | Mortality Rate (%) ± SE | Control Efficiency (%) ± SE |
|---|---|---|
| A. dest (sterile) | 13.33 ± 1.8 | 0 |
| 0.1% Neemazal | 58.00 ± 3.5 | 51.54 ± 4.08 |
| B. bassiana | 21.33 ± 5.3 | 9.23 ± 6.7 |
| N. tinuis | 19.33 ± 4.05 | 6.92 ± 4.7 |
| M. flavoviride | 54.66 ± 3.2 | 44.61 ± 3.7 |
| M. hiemalis | 24.20 ± 4.9 | 12.27 ± 5.7 |
| S. indica | 24.66 ± 4.05 | 13.08 ± 4.6 |
| Treatments | Mortality Rate (%) ± SE | Control Efficiency (%) ± SE |
|---|---|---|
| A. dest (sterile) | 17.71 ± 7.2 | 0 |
| 0.1% Neemazal | 59.42 ± 4.4 | 50.69 ± 5.3 |
| M. flavoviride 1 × 103 | 37.14 ± 6.5 | 23.61 ± 7.9 |
| M. flavoviride 1 × 105 | 57.71 ± 6.3 | 48.61 ± 7.6 |
| M. flavoviride 1 × 107 | 74.28 ± 5.3 | 68.75 ± 6.5 |
| Culture Filtrates | Chitinase Activity (Units/mL) | ||
|---|---|---|---|
| 5 d | 10 d | 20 d | |
| B. bassiana | 19.8 ± 0.05 a | 38.4 ± 4.3 a | 31.6 ± 2.9 a |
| M. flavoviride | 19.8 ± 0.16 a | 27.70 ± 3.4 a | 28.64 ± 2.1 a |
| M. hiemalis | 8.7 ± 1.3 a | 11.78 ± 0.25 b | 14.5 ± 4.5 b |
Disclaimer/Publisher’s Note: The statements, opinions and data contained in all publications are solely those of the individual author(s) and contributor(s) and not of MDPI and/or the editor(s). MDPI and/or the editor(s) disclaim responsibility for any injury to people or property resulting from any ideas, methods, instructions or products referred to in the content. |
© 2025 by the authors. Licensee MDPI, Basel, Switzerland. This article is an open access article distributed under the terms and conditions of the Creative Commons Attribution (CC BY) license (https://creativecommons.org/licenses/by/4.0/).
Share and Cite
Sabu, S.; Burow, K.; Lampert, P.; Franken, P. Efficacy of Entomopathogenic Fungi for Sustainable Biocontrol of Fungus Gnat (Bradysia difformis) in Peat-Free Substrates: A Laboratory Study. Sustainability 2025, 17, 5897. https://doi.org/10.3390/su17135897
Sabu S, Burow K, Lampert P, Franken P. Efficacy of Entomopathogenic Fungi for Sustainable Biocontrol of Fungus Gnat (Bradysia difformis) in Peat-Free Substrates: A Laboratory Study. Sustainability. 2025; 17(13):5897. https://doi.org/10.3390/su17135897
Chicago/Turabian StyleSabu, Sneha, Katja Burow, Paul Lampert, and Philipp Franken. 2025. "Efficacy of Entomopathogenic Fungi for Sustainable Biocontrol of Fungus Gnat (Bradysia difformis) in Peat-Free Substrates: A Laboratory Study" Sustainability 17, no. 13: 5897. https://doi.org/10.3390/su17135897
APA StyleSabu, S., Burow, K., Lampert, P., & Franken, P. (2025). Efficacy of Entomopathogenic Fungi for Sustainable Biocontrol of Fungus Gnat (Bradysia difformis) in Peat-Free Substrates: A Laboratory Study. Sustainability, 17(13), 5897. https://doi.org/10.3390/su17135897

